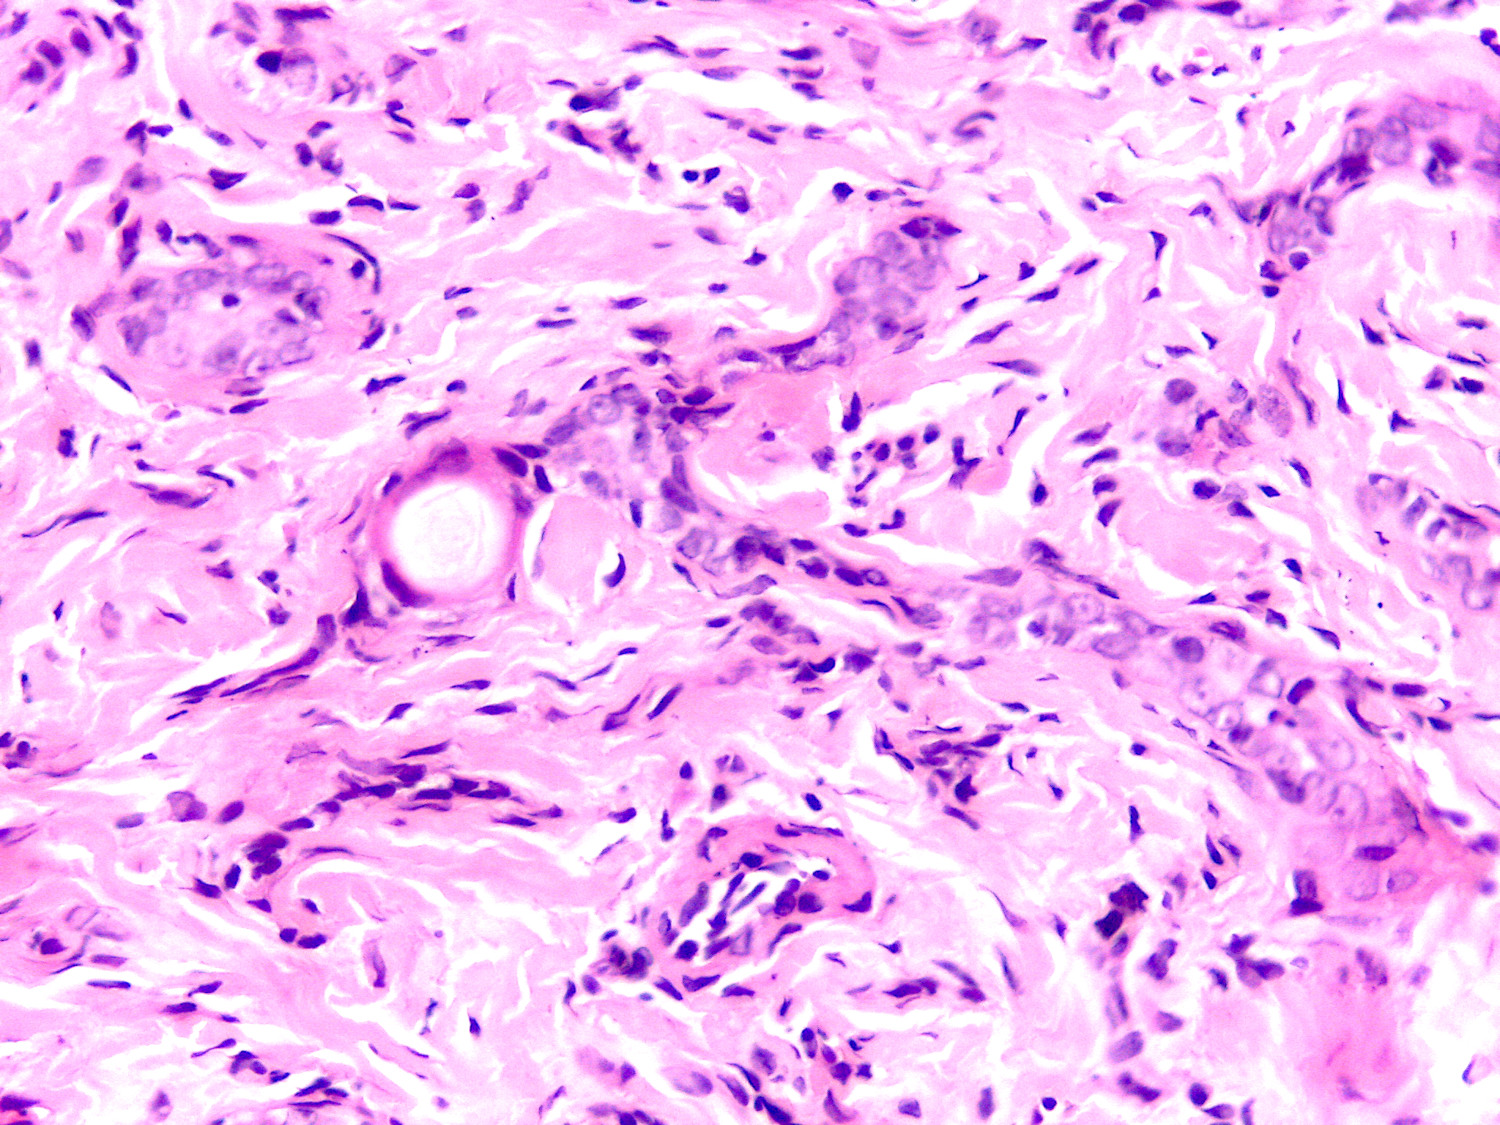
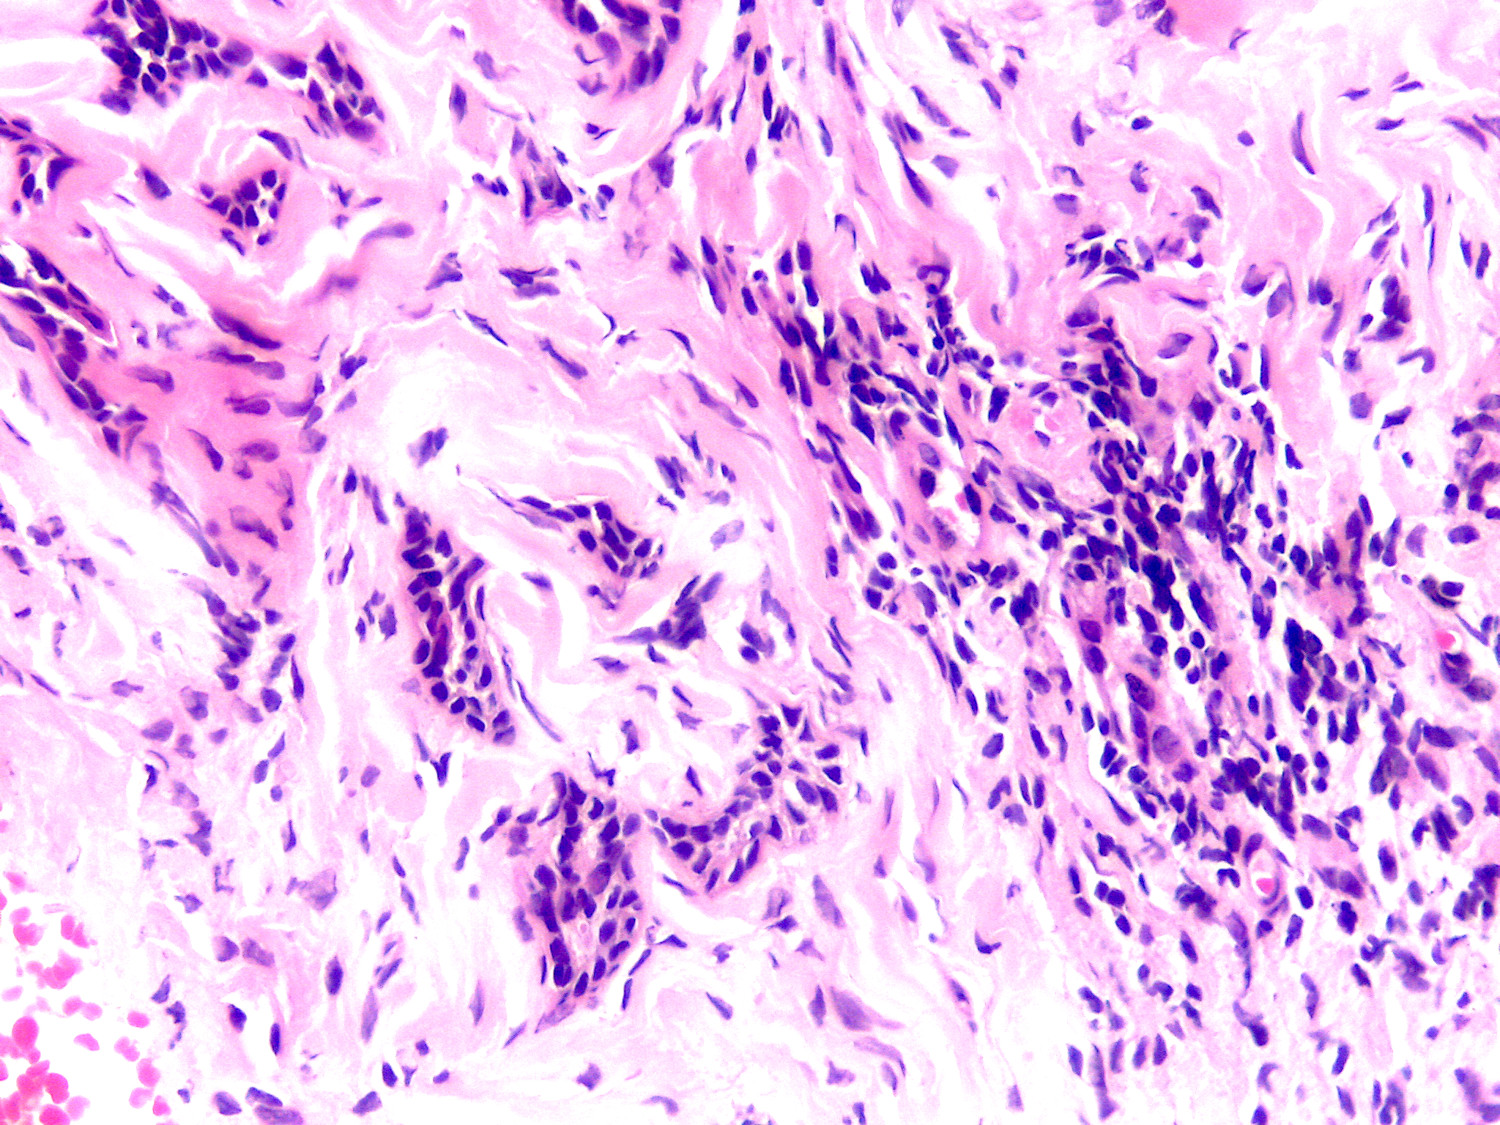
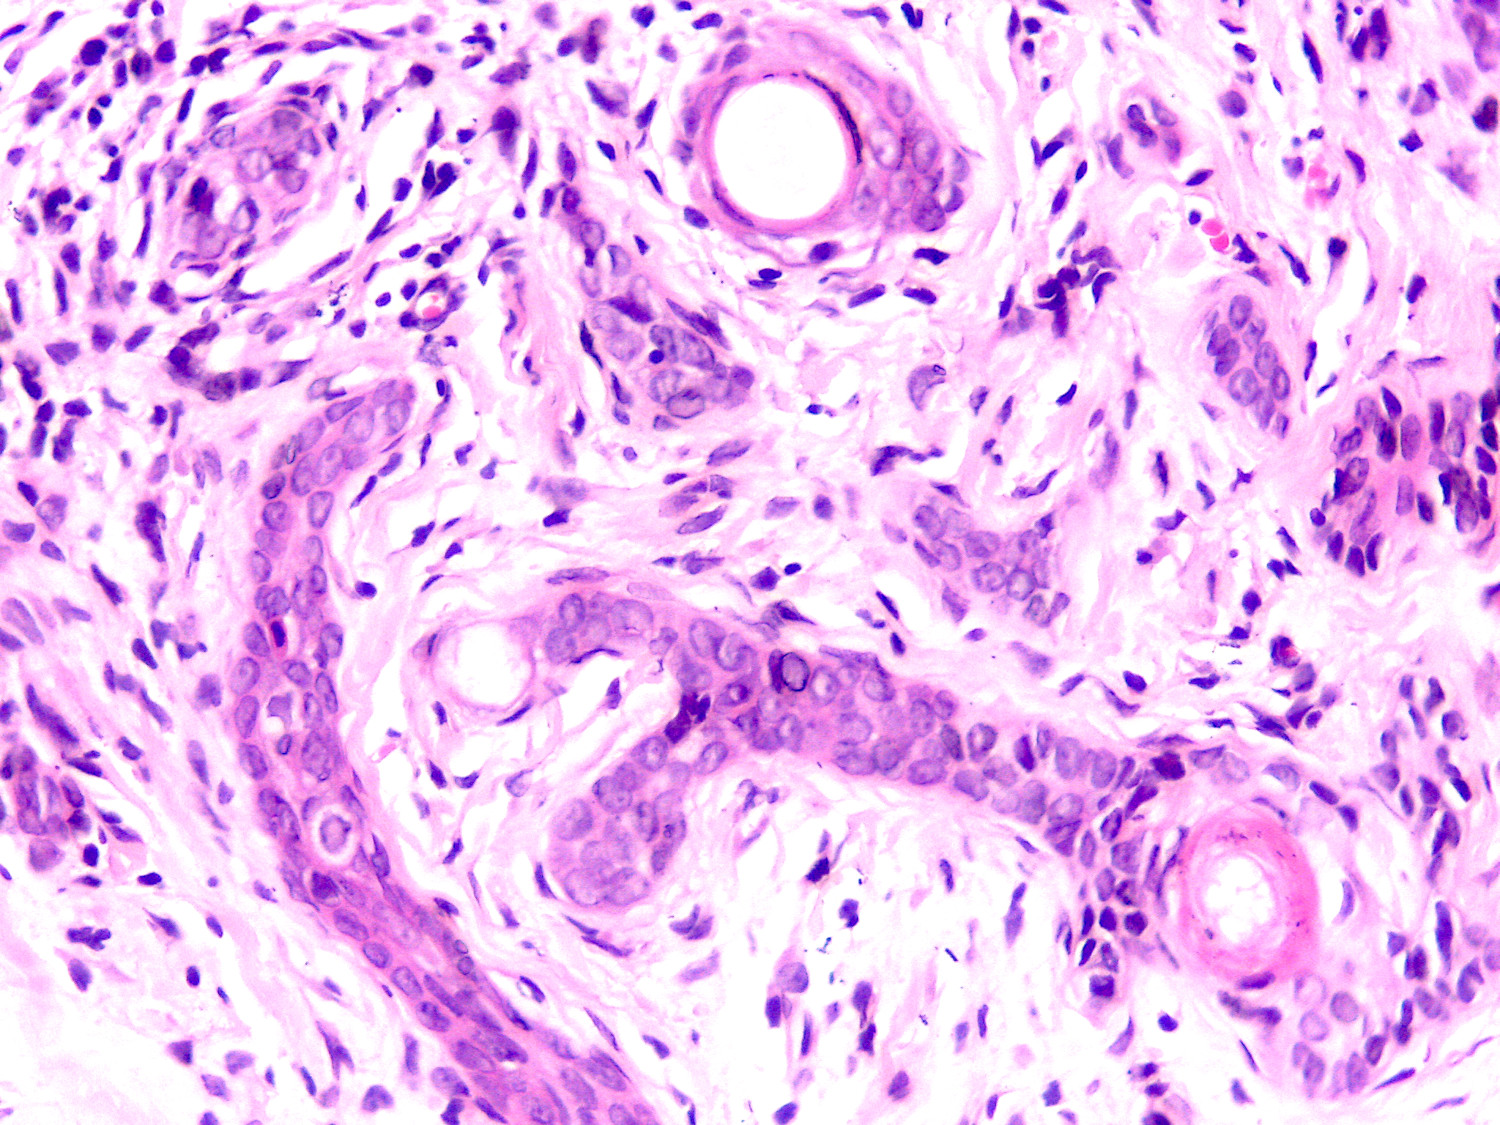

Caso del Mes cortesía Dra. Marcela Saeb Lima.
Mujer de 45 años, dermatosis localizada que afecta la mejilla, constituida por neoformación de borde elevado y centro deprimido, seis años previos en limpieza facial, fue manipulada y quemada. Clínicamente se consideró el diagnóstico de hiperplasia sebácea gigante vs carcinoma basocelular por presentar telangeictasias.
¿Cuál es su diagnóstico?, ¿cual es la trascendencia en la toma de biopsia, para el diagnóstico y prónostico precisos?